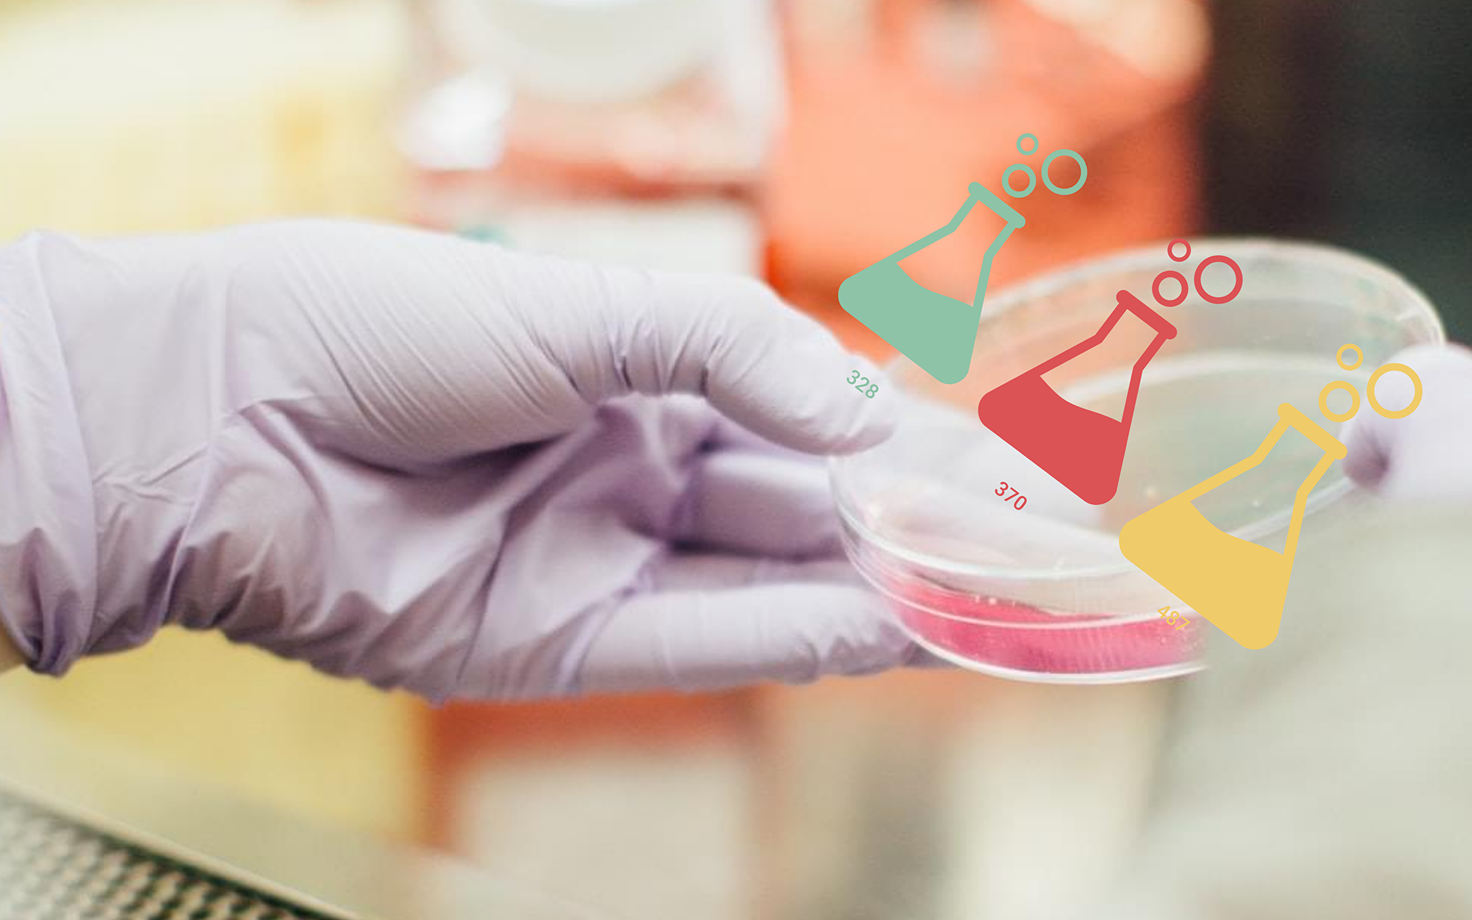
Projektitoatluste arv 2020. aastaks.

Graafikud: teadlased taotlevad raha ligi 500 projektile, kokku pea 80 miljonit eurot
Järgmisel aastal algavate uurimisprojektide esitamise tähtaeg oli 30. aprillil ning teadlased esitasid kokku 487 taotlust, mille elluviimiseks oleks vaja oleks kokku pea 80 miljonit eurot. Tegelikkuses saab neist ilmselt rahastuse 20-30 protsenti ning nendegi rahastamiseks on vaja, et teaduse rahastus riigieelarvest tervikuna tõuseks.
Rahastuse kogumaht 2020. aastal alustavatele projektidele selgub pärast riigieelarve kinnitamist.
Menetlusse võetavate taotluste arv võib jääda taotluste tehnilise kontrolli järel natuke väiksemaks, kuna taotluste hulgas võib olla selliseid, mis ei vasta taotlemise tingimustele. Mai lõpus selgub samuti taotluste lõplik valdkondlik jaotus.
Taotlusi retsenseerivad rahvusvahelised retsensendid tänavu oktoobrini ning esialgsed rahastamisettepanekud selguvad novembris. Lõplik rahastamisotsus tehakse pärast 2020. aasta riigieelarve kinnitamist.
Eesti Teadusagentuuri juhatuse esimehe Andres Koppeli sõnul tähendab esitatud taotluste hulk seda, et taas kujuneb konkurents väga tihedaks – üsna sarnaseks eelmise aastaga, mil uurimisraha sai vaid viiendik taotletud projektidest: "Loodan väga, et eelmise aasta lõpus erakondade ning teadussüsteemi osapoolte vahel sõlmitud Eesti teaduslepe püsib, järgmisel aastal teadus- ja arendustegevuse rahastamise maht kasvab ning osa sellest kasvust on võimalik suunata uurimistoetustesse. Mõistlikuks peetakse konkurssi, kus taotluste edukus on 20-30%."
Personaalne uurimistoetus on teadus- ja arendusasutuses töötava isiku või uurimisrühma kõrgetasemelise teadus- ja arendustegevuse projekti rahastamiseks eraldatav toetus. Personaalsete uurimistoetuste taotluseid menetleb Eesti Teadusagentuur ning neid rahastatakse riigieelarvest Haridus- ja Teadusministeeriumi eelarve kaudu.



















